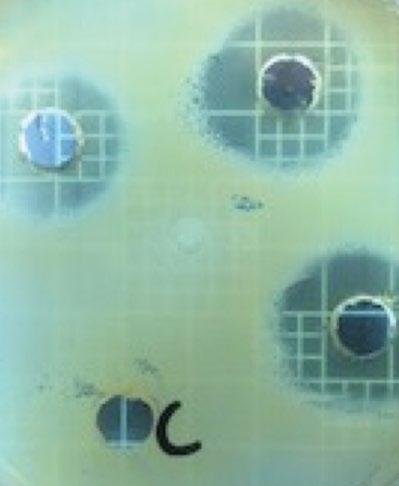

de bacterias ácido
lácticas
Por: Daniela Arrioja-Bretón · Emma Mani-López · Enrique Palou · Aurelio López-Malo
Actualmente existe una tendencia en la preferencia de los consumidores por elegir alimentos frescos y menos procesados, por lo que ha surgido el interés en buscar conservadores diferentes a los sintéticos y asegurar la inocuidad de los alimentos. Con este propósito se han estudiado algunos bioconservadores, entre los que destacan los aceites esenciales, enzimas y microorganismos (Beristain-Bauza et al., 2012, 2017; Mani-López et al., 2017). Entre estos últimos se encuentran las bacterias ácido-lácticas (bal ), las cuales, además de producir sabores, olores, texturas y cambios nutricionales en los alimentos,
también son conocidas por su capacidad de producir metabolitos secundarios tales como ácidos orgánicos, bacteriocinas, peróxido de hidrógeno, reuterina, diacetilo y alcohol etílico, entre otros. Varios estudios han demostrado que la aplicación directa de las bal o de sus metabolitos inhiben bacterias indeseables en alimentos (Mani-López et al., 2018).
El objetivo de este estudio fue evaluar la efectividad como antimicrobianos de diferentes cepas de bal (sobrenadantes libres de células) contra Escherichia coli, Staphylococcus aureus, Salmonella Typhimurium y Listeria monocytogenes. Se evaluó la actividad antimicrobiana mediante una prueba de difusión en pozos de los sobrenadantes de doce cepas de bal .
METODOLOGÍA
Las cepas de las bal (Lactococcus lactis subsp. lactis NRRL B-633, Lactococcus lactis subsp. cremoris NRRL B-634, Pediococcus acidilactici NRRL B-1116, Pediococcus pentosaceus NRRL B-14009, Leuconostoc mesenteroides subsp. mesenteroides NRRL B-1118, Lactobacillus sakei NRRL B-1917, Lactobacillus fermentum NRRL B-1932, Lactobacillus reuteri NRRL B-14171, Lactobacillus plantarum NRRL B-4496, Lactobacillus acidophilus NRRL B-4495, Lactobacilus casei NRRL B-1922 y Lactobacillus rhamnosus NRRL B-442), así como las cepas de las bacterias indicadoras (Escherichia coli ATCC 25922, Staphylococcus aureus ATCC 29413, Salmonella Typhimurium ATCC 14028 y Listeria monocytogenes Scott A) fueron obtenidas de la colección de cepas del laboratorio de Microbiología de Alimentos de la Universidad de las Américas Puebla, y se mantuvieron a 5°C en agar MRS y en agar soya tripticaseína, respectivamente.
Los cultivos fueron preparados inoculando las cepas de las bal en 30 mL de caldo MRS y las bacterias indicadoras en 10 mL de caldo soya tripticaseína, se incubaron a 35°C durante 24 h. Para la obtención del sobrenadante de las bal , los cultivos fueron centrifugados durante diez minutos a 10,000 rpm. Posteriormente se filtraron al vacío a través de una membrana HVLP de 0.45 μm, para después concentrar hasta reducir el volumen a la décima parte del original, en un rotavapor a una temperatura de 70°C.
La actividad antimicrobiana de los sobrenadantes de las bal se evaluó a través de una prueba de difusión en pozos sobre placas de agar, la cual consiste en realizar una siembra por extensión de los microrganismos indicadores (105 UFC/g) en cajas Petri con agar soya trip-
LAS CEPAS DE LAS BAL Y LAS CEPAS DE LAS BACTERIAS INDICADORAS
fueron obtenidas de la colección de cepas del laboratorio de Microbiología de Alimentos de la Universidad de las Américas Puebla, y se mantuvieron a
EN AGAR MRS Y EN AGAR SOYA TRIPTICASEÍNA
SE INCUBARON A 35°C DURANTE 24 HORAS 5°C 30 10 mL mL
los cultivos fueron preparados inoculando las cepas de las bal en
DE CALDO MRS Y LAS BACTERIAS INDICADORAS EN
EN DE CALDO SOYA TRIPTICASEÍNA
Arrioja-Bretón D. et al. Entorno udlap núm. 5, 58-61, Mayo 2018
Lactococcus lactis subsp. cremoris
Lactococcus lactis subsp. lactis
-No se observaron halos de inhibición.
ticaseína solidificado, posteriormente se realizaron cuatro perforaciones. En tres de los pozos se colocó el sobrenadante; en el cuarto se colocó caldo MRS concentrado, como control negativo. Las placas se incubaron a 37°C durante 24 horas y, posteriormente, se midió el diámetro de los halos de inhibición con un calibrador Vernier digital; se realizaron tres mediciones a cada uno de los halos de inhibición. Todas las pruebas se realizaron por duplicado.
RESULTADOS
El efecto de los sobrenadantes de las doce bal producto del crecimiento en un medio líquido, contra las diferentes bacterias indicadoras, se muestra en la tabla 1. Se puede observar que los sobrenadantes producidos por Lb. plantarum NRRL B-4496, Lb. sakei NRRL B-1917 y Lb. rhamnosus NRRL B-442 son los que presentaron halos de inhibición más grandes contra las bacterias indicadoras, siendo el sobrenadante de Lb. plantarum NRRL B-4496 el que presenta mayor inhibición contra S. Typhimurium ATCC 14028, mientras que para S. aureus ATCC 29413, E. coli ATCC 25922 y L. monocytogenes Scott A se
Figura 1. Prueba de difusión en pozos del sobrenadante de Lb. sakei NRRL B-1917 contra L. monocytogenes
Scott A.
De acuerdo con otros estudios semejantes, Anas et al. (2008) observaron que los sobrenadantes de Lb. plantarum, Lb. paracasei subsp. paracasei y Lb. rhamnosus son capaces de inhibir el crecimiento de Staphylococcus aureus ATCC 25923, siendo los sobrenadantes de Lb. plantarum los que destacaron en la reducción de la población patógena. Beristain-Bauza et al. (2016, 2017) reportan que los sobrenadantes de Lb. sakei y Lb. rhamnosus tienen un efecto inhibitorio en la población de microorganismos patógenos Gram positivos y Gram negativos (Escherichia coli ATCC 25922, Staphylococcus aureus ATCC 29413, Salmonella Typhimurium ATCC 14028 y Listeria monocytogenes Scott A). Por otro lado, observaron que al Staphylococcus aureus
aumentar la concentración de los sobrenadantes, la reducción logarítmica de los microorganismos patógenos es mayor. Se puede concluir que los sobrenadantes obtenidos del crecimiento en un medio líquido de la mayoría de las bacterias ácido lácticas evaluadas, presentan inhibición contra bacterias Gram positivas y Gram negativas. Los sobrenadantes que presentan mayor inhibición son los de las cepas de Lb. sakei NRRL B-1917 y Lb. plantarum NRRL B-4496, seguido de los sobrenadantes de Lb. rhamnosus NRRL B-442 Los sobrenadantes, producto del crecimiento de las bacterias ácido lácticas, podrían ser una alternativa de bio-conservadores, por lo que se requiere mayor investigación sobre su aplicación y comportamiento al ser añadidos en alimentos, así como su capacidad de inhibir o reducir la proliferación de diversos microorganismos patógenos, no sólo los estudiados en el presente trabajo.
AGRADECIMIENTOS
Daniela Arrioja-Bretón agradece a la Universidad de las Américas Puebla (udlap ) por el financiamiento para sus estudios de Doctorado en Ciencia de Alimentos.
REFERENCIAS
observó una mayor inhibición con los sobrenadantes producidos por Lb. sakei NRRL B-1917, esto puede ser debido a la presencia de metabolitos como ácidos orgánicos, peróxido de hidrógeno, dióxido de carbono, el diacetilo, entre otros (Anas et al., 2008). También se observó que, de las cuatro bacterias indicadoras, la más sensible a los sobrenadantes de las bal estudiadas fue L. monocytogenes Scott A (figura 1).
• Anas, M., Eddine, H.J. y Mebrouk, K. (2008). Antimicrobial activity of Lactobacillus species isolated from Algerian raw goat’s milk against Staphylococcus aureus. World Journal of Dairy and Food Sciences. 3(2), 39-49
Beristain-Bauza, S.C. Palou, E., y López-Malo, A. (2012). Bacteriocinas: antimicrobianos naturales y su aplicación en los alimentos. Temas Selectos de Ingeniería de Alimentos, 6(2), 64-78.
Beristain-Bauza, S.C., Mani-López, E., Palou, E. y López-Malo, A. (2016). Antimicrobial activity and physical properties of protein films added with cell-free supernatant of Lactobacillus rhamnosus. Food Control, 62 44-51.
Beristain-Bauza, S.C., Mani-López, E., Palou, E. y López-Malo, A. (2017). Antimicrobial activity of whey protein films supplemented with Lactobacillus sakei cell-free supernatant on fresh beef. Food Microbiology, 62 207-211.
Mani-López, E., Palou, E. y López-Malo, A. (2018). Chapter 8: Biopreservatives as agents to prevent food spoilage. Microbial Contamination and Food Degradation. Handbook of Food Bioengineering. Volume 10. A.M. Grumezescu, A.M. Holban (Editors). Academic Press. pp. 235-270.

Daniela Arrioja-Bretón Estudió la Licenciatura en Nutrición y Ciencia de los Alimentos en la Universidad Iberoamericana (2011), actualmente es estudiante del Doctorado en Ciencia de Alimentos en la udlap Su área de investigación es la microbiología de alimentos y estudia la actividad antimicrobiana de bacterias ácido lácticas como posible fuente de bioconservadores.daniela.arriojabn@udlap.mx

Emma Mani-López Doctora en Ciencia de los Alimentos por el Instituto Tecnológico de Veracruz, ingeniera de Alimentos y maestra en Ciencia de Alimentos por la udlap. Actualmente es investigadora en diversos proyectos financiados por la industria en vinculación con el Departamento de Ingeniería Química y Alimentos de la udlap. Es investigador nacional (conacyt) actualmente SNI nivel 1, y sus intereses de investigación son los agentes antimicrobianos, bacteriocinas y su posible aplicación en alimentos. emma.mani@udlap.mx

Enrique Palou Doctor en Ingeniería por la Universidad Estatal del Estado de Washington (EE.UU.) y catedrático del Departamento de Ingeniería Química y Alimentos en la udlap desde 1992. Tiene más de 170 publicaciones científicas en el área de ciencia, tecnología e ingeniería de alimentos. Es investigador nacional (SNI) nivel 3, Fellow del Institute of Food Technologists, miembro de la Academia Mexicana de Ciencias y de la Academia de Ingeniería. enrique.palou@udlap.mx

Aurelio López-Malo Doctor en Química (Alimentos) por la Universidad de Buenos Aires (Argentina) y profesor del Departamento de Ingeniería Química y Alimentos de la udlap desde 1987. Ha publicado más de doscientos artículos científicos en revistas indizadas de prestigio internacional en el área de ciencia, tecnología e ingeniería de alimentos. Desde 1998 es investigador nacional (conacyt) actualmente SNI nivel 3, y es miembro de la Academia Mexicana de Ciencias. aurelio.lopezm@udlap.mx
